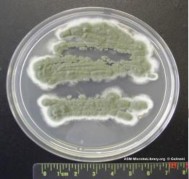
Lactococcus lactis Pennicillium roqueforti Hình 5 4 Hình ảnh một số VSV sử dung trong 4

caseinglucopeptide trên bề mặt của chúng. Kết quả là tốc độ đông tụ sữa cũng sẽ gia tăng. Thực nghiệm cho thấy nhiệt độ tối ưu cho quá trình đông tụ casein trong sữa khoảng 42,5÷45,00C.
* Calcium
Theo Law B. A (1999), ion Ca sẽ làm giảm điện tích các casein do chúng tạo liên kết với các nhóm tích điện trong phân tử casein, do đó sẽ làm giảm lực đẩy tĩnh điện giữa các micelle với nhau và giúp cho quá trình đông tụ sữa diễn ra nhanh và dễ dàng hơn.
Trong sản xuất, người ta thường sử dụng muối CaCl2 để bổ sung vào sữa trước khi thực hiện quá trình đông tụ. Hàm lượng dùng từ 5÷20g cho 100kg sữa tươi. Việc bổ sung CaCl2 có thể làm giảm nhẹ pH sữa. Hiện tượng này cũng có lợi cho quá trình đông tụ.
Nếu bổ sung calcium với hàm lượng quá cao, khối đông tụ trở nên cứng hơn và có thể gây khó khăn cho việc cắt khối đông và các giai đoạn chế biến tiếp theo trong sản xuất phomat. Đối với những sản phẩm phomat có hàm lượng chất béo thấp, ở một số nước, người ta bổ sung natri phosphate Na2HPO4 vào sữa (hàm lượng 10÷20g/kg) trước khi cho CaCl2 vào. Khi đó, độ dẻo của khối đông được cải thiện đáng kể do sự tạo thành dạng keo Ca3(PO4)2, chúng có chức năng tạo độ dẻo cho khối đông tương tự như các hạt cầu béo.
* CO2
CO2 có thể tìm thấy trong sữa tươi. Việc bổ sung CO2 vào sữa sẽ làm giảm pH tự nhiên của sữa xuống 0,1÷0,3 đơn vị. Khi đó, thời gian đông tụ sữa được rút ngắn. Theo Bylund Gosta (1995), việc bổ sung CO2 vào sữa cho phép chúng ta tiết kiệm được một lượng nhỏ enzyme đông tụ sữa cần dùng mà thời gian đông tụ vẫn không thay đổi.
2. VI SINH VẬT
2.1. Vi sinh vậ t trong sữ a bò
Trong cơ thể động vật, sữa tươi được tuyến vú tổng hợp không chứa vi sinh vật. Tuy nhiên, khi kiểm tra sữa mới vắt ta thường phát hiện có rất nhiều nhóm vi sinh vật khác nhau, nguồn gốc của các vi sinh vật này xuất phát từ: bầu vú của động vật cho sữa, người vắt sữa, thiết bị vắt sữa, môi trường chuồng trại nơi diễn ra quá trình vắt sữa.
Hệ vi sinh vật và số lượng của chúng luôn luôn thay đổi và phụ thuộc vào mức độ nhiễm vi sinh vật trong quá trình vắt sữa. Các vi sinh vật có trong sữa bao gồm cả vi khuẩn, nấm men và nấm mốc.
2.1.1. Vi khuẩn
a) Vi khuẩn lactic: là loại vi khuẩn phổ biến trong tự nhiên, nhiệt độ sinh trưởng tối ưu trong khoảng 25÷470C. Để tồn tại trong môi trường sữa, vi khuẩn lactic tổng hợp năng lượng ATP từ cơ chất lactose. Acid lactic là một trong những sản phẩm được sinh ra từ quá trình tổng hợp năng lượng. Dựa vào nhóm sản phẩm được tổng hợp từ quá trình trao đổi năng lượng, người ta chia vi khuẩn lactic thành hai nhóm:
- Vi khuẩn lactic đồng hình: acid lactic là sản phẩm chính và hàm lượng của nó chiếm tỷ lệ vượt trội hơn nhiều so với các sản phẩm phụ khác.
- Vi khuẩn lactic dị hình; các sản phẩm được tạo thành từ quá trình chuyển hóa đường gồm có acid lactic, acid acetic, ethanol, khí CO2,... Hàm lượng acid lactic thu
được không cao hơn nhiều so với hàm lượng các sản phẩm còn lại.
Trong công nghệ lên men các sản phẩm từ sữa như yoghurt, kefir, phomat và một số loại bơ, người ta sử dụng các loại vi khuẩn lactic để thực hiện một số chuyển hóa cần thiết. Giống vi khuẩn lactic trong sản xuất công nghiệp là những canh trường vi sinh vật thuần khiết được nhân lên qua nhiều cấp từ một tế bào vi khuẩn ban đầu đã qua tuyển chọn. Còn các vi khuẩn lactic có mặt trong sữa tươi sau khi vắt được xem là những vi sinh vật tạp nhiễm. Chúng sẽ tạo ra những chuyển hóa ngoài ý muốn của nhà sản xuất trong quá trình bảo quản sữa trước khi chế biến (giảm pH, đông tụ casein, tạo các hợp chất mới trong sữa như ethanol, acid acetic,... làm thay đổi thành phần và giá trị cảm quan của sữa). Các vi khuẩn lactic nhiễm vào sữa thuộc nhiều giống khác nhau như: Streptococcus, Lactococcus, Lactobacillus, Leuconostoc, Bifidobacterium,...
Chúng gồm các nhóm vi khuẩn lên men đồng hình lẫn dị hình. Khi thanh trùng ở 800C, hầu hết các vi khuẩn lactic nhiễm trong sữa sẽ bị tiêu diệt.
b) Vi khuẩn Coliform: trong sữa, vi khuẩn Coliform sẽ chuyển hóa đường lactose tạo acid lactic và các acid hữu cơ khác, khí CO2, H2,... Chúng cũng phân giải protein trong sữa tươi tạo ra các sản phẩm khí làm cho sữa có mùi khó chịu. Ở nhiệt độ 750C trong
khoảng thời gian 20 giây, vi khuẩn Coliform sẽ bị tiêu diệt.
c) Vi khuẩn sinh acid butyric (giống Clostridium): chuyển hóa đường trong sữa thành nhiều sản phẩm khác nhau như: acid butyric, butanol, ethanol, khí CO2, H2,... làm thay đổi thành phần hóa học và giá trị cảm quan của sữa trong quá trình bảo quản. Các bào tử Clostridium khá bền với nhiệt, quá trình thanh trùng sữa không thể tiêu diệt được hoàn toàn các bào tử Clostridium chịu nhiệt. Khi đó, ta phải dùng giải pháp kỹ thuật khác như vi lọc, ly tâm hoặc sử dụng chất kháng khuẩn để loại bỏ hoặc ức chế Clostridium.
d) Vi khuẩn propionic (giống Propionibacterium): chuyển hóa đường thành acid propionic, acid acetic, khí CO2, ... làm hư hỏng sữa. Tuy nhiên, trong công nghệ sản xuất một số loại phomat như Emmenthal, Gruyere... người ta sử dụng canh trường Propionibacterium thuần khiết để tạo ra cấu trúc lỗ hổng và hương vị đặc trưng cho sản phẩm. Hầu hết các loại vi khuẩn propionic bị tiêu diệt khi thanh trùng sữa ở 750C trong thời gian 20 giây.
e) Vi khuẩn gây thối: là các vi khuẩn có khả năng sinh tổng hợp protease ngoại bào trong môi trường sữa. Protease sẽ xúc tác quá trình thủy phân protein tạo ra các sản phẩm polypeptide, peptide và acid amin. Một số acid amin tiếp tục bị phân giải tạo NH3, H2S,... làm cho sữa có mùi khó chịu.
Vài giống vi khuẩn gây thối có khả năng sinh tổng hợp lipase ngoại bào. Enzyme này xúc tác quá trình thủy phân các chất béo trong sữa và tạo ra nhiều sản phẩm có mùi ôi. Các giống vi khuẩn gây thối thường gặp trong sữa là: Pseudomonas, Brevibacterium, Achromobacter, Alcaligenes, Bacillus, Micrococcus,... Đáng chú ý là loài Pseudomonas fluorescens. Các enzyme protease và lipase được sinh tổng hợp bởi loài vi khuẩn này rất bền nhiệt. Chúng là nguyên nhân chính gây nên quá trình phân giải protein và lipid. Ngoài ra một số vi khuẩn gây thối còn tạo khí (CO2, H2,...) sinh tổng hợp các acid hữu cơ làm giảm pH sữa và gây đông tụ protein. Một số vi khuẩn khác có thể sinh tổng hợp được protease có chức năng xúc tác tương tự như chymosin làm xuất hiện sự đông tụ trong sữa.
2.1.2. Nấm men (yeasts)
Một số loại nấm men thường gặp trong sữa như: Saccharomyces cerevisiae,
Kluyveromyces marxianus, Debaromyces hansenii, Torulopsis lactis condensi,... Nhiều loại nấm men thuộc nhóm kỵ khí tùy tiện.
Một số nấm men có thể sử dụng đường lactose trong quá trình trao đổi chất. Chúng phát triển trong sữa và gây ra những biến đổi về thành phần hóa học trong quá trình bảo quản sữa.
2.1.3. Nấm sợi (moulds)
Một số loại nấm sợi thường nhiễm vào sữa, bao gồm: Penicillium camembertii, P.roquefortii, P.casei, Geotrichum cadidum, Rhizopus stolonifer,... Trong số các nấm sợi nói trên, vài loài thuộc giống Penicillium được sử dụng trong sản xuất một số loại phomat. Việc nhiễm nấm sợi vào sữa gây nhiều khó khăn trong công nghệ chế biến sữa, đặc biệt là trong sản xuất phomat và ảnh hưởng xấu đến chất lượng của sản phẩm.
Tuy nhiên, khác với nhóm vi khuẩn sinh bào tử chịu nhiệt, hầu hết các loại nấm men và nấm sợi đều bị tiêu diệt trong quá trình thanh trùng sữa ở 750C trong thời gian 10÷15 giây. Vấn đề quan trọng là phải tuân thủ nghiêm ngặt các quy định về vệ sinh để tránh hiện tượng tái nhiễm vi sinh vật vào sữa sau khi đã thanh trùng.
2.2. Vi sinh vậ t lên men sữa
Để sản xuất các sản phẩm sữa lên men, người ta cấy các chủng VSV khác nhau vào sữa, kết quả là chuyển hóa lactose thành acid lactic, CO2, acid acetic, diacetyl, acetaldehyt và các hợp chất bay hơi khác, tạo cho sản phẩm có mùi vị đặc trưng. Một số sản phẩm như kefir, kumis còn chứa một lượng nhỏ ethanol. Quá trình lên men chuyển lactose thành acid lactic có tác dụng bảo quản sữa rất tốt, bởi lẽ pH thấp khống chế sự phát triển của vi khuẩn gây thối và các vi khuẩn có hại khác.
Hệ VSV dùng để lên men sữa đã được biết đến từ khá lâu. Chủng VSV có thể chỉ bao gồm một loài hoặc hỗn hợp của nhiều loài. Một số loài như Streptococcus lactic, S.cremoric, S.thermophilus chỉ có tác dụng lên men lactose và tạo ra acid lactic. Một số khác như S.diacetyllactic, Leuconostoc citrovorum lại có khả năng tạo chất thơm. Hình ảnh một số VSV trong lên men sữa được mô tả ở hình 5.4.


(Streptococcus thermophilus) (Lactobacillus bungaricus)

(Lactococcus lactis) (Pennicillium roqueforti)
Hình 5.4. Hình ảnh một số VSV sử dung trong lên men sữa
Việc sử dụng loại vi khuẩn nào, với tỷ lệ bao nhiêu để cho kết quá tốt nhất là mối quan tâm của các nhà sản xuất. Trên thị trường có rất nhiều loại chủng khác nhau về thành phần vi khuẩn, tỷ lệ giữa chúng, trạng thái. Tùy theo nhu cầu và điều kiện sản xuất mà người ta chọn phương án thích hợp nhất. Một số VSV sử dụng trong lên men sữa được trình bày ở bảng 5.13.
Bảng 5.13. Vi sinh vật sử dụng trong sản xuất các sản phẩm lên men từ sữa (Oberman H. và Libudzisz.Z, 1998)
Loại | Giống VSV | Loại | |
Vi khuẩn | Vi khuẩn | ||
Lactobacillus | L.delbrueckii L.delbrueckii ssp lactis L.delbrueckii ssp bulgaricus L.helveticus L.acidophilus L.casei L.kefir | Streptococcus | S.thermophilus |
Pediococcus | P.pentosaceus, P.acidilactis | ||
Acetobacter | A.aceti | ||
Nấm men | |||
Kluyveromyces | K.marxianus ssp marxianus K. marxianus ssp bulgaricus K.lactis | ||
Lactococcus | L.lactis ssp lactis L.lactis ssp lactis var Diacetylatis L.lactis ssp cremoris | ||
Candida | C.kefir | ||
Leuconostoc | L.mesenteroides L.mesenteroides ssp Dextranicum L. mesenteroides ssp Cremoris | Saccharomyces | S.cerevisiae S.lactis |
Torulaspora | T.delbrueckii | ||
Nấm sợi | |||
Geotrichum | G.candidum | ||
Có thể bạn quan tâm!
-
Công nghệ lên men thực phẩm Phần 2 - Trường CĐ Lương thực Thực phẩm - 1 -
Công nghệ lên men thực phẩm Phần 2 - Trường CĐ Lương thực Thực phẩm - 2 -
Quy Trì Nh Công Nghệ Tổng Quát Sả N Xuấ T Yoghurt -
Nấm Men Và Acid Lactic Tại Bề Mặt Của Một Hạt Kefir -
÷350C) Và Ưa Nhiệt (Topt= 37÷450C) Vớ I Cơ Chế Lên Men Đồ Ng Hì Nh Ho Ặc Dị Hình .
Xem toàn bộ 105 trang tài liệu này.
Vi khuẩn lactic là loại đặc trưng trong chế biến sữa, chúng bao gồm cả bacilli và cocci. Đa số vi khuẩn này bị tiêu diệt ở 700C, một số thì chỉ bị tiêu diệt ở 800C.
Khả năng lên men của các loài vi khuẩn khác nhau là không giống nhau. Phần lớn các vi khuẩn lactic có khả năng tạo thành từ 0,5÷1,5% acid lactic, một số loài có thể tạo ra nhiều hơn (tới 3,0%). Để phát triển các vi khuẩn lactic cần nguồn nitơ hữu cơ. Chúng sử dụng nguồn này từ quá trình chuyển hóa casein do tác dụng của các protease. Khả năng thủy phân casein phụ thuộc vào từng loại. Trong số các vi khuẩn lactic có Streptococcus diacetylactic và Lactococcus citrovorum có thể lên men lactic đến cacbon dioxyt và diacetyl. Cacbon dioxyt do vi khuẩn tạo thành từ quá trình lên men acid citric và lactose được tập trung ở những khoảng trống trong phomat, tạo thành các lỗ rỗng. Cacbon dioxyt tạo mùi rất đặc trưng cho chủng đầu, chủng sử dụng và sản phẩm lên men. Diacetyl tạo thành từ lên men acid citric làm tăng mùi rất đặc trưng của chủng men cái, các sản phẩm sữa lên men và bơ. Lactobacillus helveticus và Bacillus rất quan trọng trong quá trình chín của phomat Emmenthal.
3. CÔNG NGHỆ SẢ N XUẤ T SỮ A CHUA YOGHURT
3.1. Giớ i thiệ u chung
Sữa chua yoghurt là sản phẩm sữa chua được biết nhiều nhất và cũng là sản phẩm phổ biến trên khắp thế giới. Sữa chua yoghurt bắt nguồn từ Bugari với tên gọi là yaourt, ở nhiều nước khác có tên gọi riêng cho yoghurt. Trạng thái, mùi vị của sữa chua yoghurt có khác nhau ở vùng này so với vùng khác. Đặc biệt là độ đặc hoặc loãng phụ thuộc vào thị hiếu của mỗi nước.
Ở Việt Nam, sản phẩm sữa chua lên men yoghurt rất đa dạng, phổ biến có các loại như sữa chua đặc, sữa chua uống, sữa chua có bổ sung thêm calcium, chất xơ, …
3.2. Phân loại sữa chua yoghurt
Trên thị trườ ng hiệ n nay , sản phẩm yoghurt rất đa dạng về chủng loại , dự a và o quy trì nh công nghệ và đặ c tí nh củ a sả n phẩ m có thể phân loạ i như sau :
- Yoghurt truyền thống (set type): là sản phẩm có cấu trú c gel mị n , dạng khối đông đồng nhất . Trong quy trì nh sả n xuấ t , sữ a nguyên liệ u sau khi đượ c xử lý , cấ y giố ng rồ i đượ c ró t và o bao bì . Quá trình lên men diễn ra trong bao bì làm xuất hiện khố i đông và tạ o cấ u trú c đặ c trưng cho sản phẩm (hình 5.5).
- Yoghurt dạ ng khuấ y (stirred type): không có cấu trúc gel mịn và đồng nhất, khố i đông xuấ t hiệ n trong sả n phẩ m sau quá trì nh lên men bị phá hủ y do sự khuấ y trộ n cơ họ c. Trong quy trì nh sả n xuấ t , sữa nguyên liệ u sau khi đượ c xử lý , cấ y giố ng rồ i lên men trong thiế t bị chuyên dù ng , tiế p theo là quá trì nh là m lạ nh và ró t sả n phẩ m và o bao bì (hình 5.6).
VSV
VSV
Sữa đã chuẩn bị
1
2
3
Sữa đã chuẩn bị
1
2
3
Hình 5.5. Yoghurt truyền thống
1. Rót hộp; 2. Lên men; 3. Làm lạnh nhanh
Hình 5.6. Yoghurt dạng khuấy
1. Lên men; 2. Làm lạnh; 3. Rót hộp
- Yoghurt uố ng (drink type): khố i đông xuấ t hiệ n trong sả n phẩ m sau quá trì nh lên men bị phá hủ y hoà n toà n . Sản phẩm có dạng lỏng. Sau quá trì nh lên men, ngườ i ta sử dụ ng phương phá p khuấ y trộ n hoặ c phương phá p đồ ng hó a để phá hủ y cấ u trú c gel của khối đông và làm giảm độ nhớt cho sản phẩm (hình 5.7).
- Yoghurt lạ nh đông (frozen yoghurt): có dạng tương tự như kem . Quá trình lên men sữ a đượ c thự c hiệ n tr ong thiế t bị chuyên dù ng , hỗ n hợ p sau lên men đượ c đem đi xử lý và lạ nh đông để là m tăng độ cứ ng cho sả n phẩ m rồ i bao gó i (hình 5.8).
1
3
VSV
4
VSV
2
Sữa đã chuẩn bị
2
3
Sữa đã chuẩn bị
1
Hình 5.7. Yoghurt uống
Hình 5.8. Yoghurt lạnh đông
1. Lên men; 2. làm lạnh; 3. Đồng hóa; 4. Rót hộp 1. Lên men; 2. Làm lạnh đông; 3. Tạo hình
VSV
1
2
3
- Yoghurt cô đặ c (concentrated yoghurt): quy trì nh sả n xuấ t bao gồ m cá c giai đoạ n quan trọ ng như lên men sữ a , cô đặ c , làm lạnh và bao gói sản phẩm . Trong qua trình cô đặc, tách bớt huyết thanh sữ a ra khỏ i sả n phẩ m rồi làm lạnh (hình 5.9).
Sữa đã chuẩn bị
Hình 5.9. Yoghurt cô đặc
1. Lên men; 2. Tách nước sữa; 3. Rót hộp
Theo tổ chứ c y tế thế giớ i WHO và tổ chứ c Nông lương FAO , sản phẩm yoghurt có thể chia thành ba nhóm sau:
- Yoghurt béo: hàm lượng chất béo trong sản phẩm không thấp hơn 3%
- Yoghurt “bá n gầ y”: hàm lượng chất béo trong sản phẩm khoảng 0,5÷3%
- Yoghurt gầ y: hàm lượng chất béo trong sản phẩm không lớn hơn 0,5%
Sau quá trình lên men, yoghurt có chứa sinh khối vi khuẩn lactic và một số enzyme ngoại bào do chúng tiết ra. Do đó, sản phẩm phải được bảo quản ở nhiệt độ thấp (2÷40C) để hạn chế những biến đổi bất lợi có thể làm thay đổi mùi, vị và các chỉ tiêu chất lượng khác của yoghurt. Các vi khuẩn lactic có trong yoghurt rất có lợi cho quá trình tiêu hóa thức ăn ở cơ thể người. Ngoài các giá trị dinh dưỡng thông thường, một số nhà khoa học đã cho rằng sữa lên men yoghurt còn có chức năng làm chậm quá trình lão hóa và kéo dài tuổi thọ cho người sử dụng.
Để kéo dài thời gian bảo quản và giảm chi phí trong việc vận chuyển, bảo quản sản phẩm, người ta có thể sử dụng quá trình thanh trùng hoặc tiệt trùng UHT trong quy trình công nghệ sản xuất một số dạng yoghurt. Khi đó, nhóm vi khuẩn lactic và các VSV nhiễm vào sản phẩm sẽ bị tiêu diệt hoặc ức chế. Yoghurt uống dạng lỏng qua xử lý tiệt trùng UHT có thể bảo quản ở nhiệt độ phòng.
Tuy nhiên một số quốc gia hiện nay không cho phép sử dụng nhiệt độ cao để tiêu diệt hoặc ức chế nhóm vi khuẩn lactic trong sản phẩm nhằm giữ lại những giá trị cho sản phẩm yoghurt và những lợi ích do nhóm vi khuẩn lactic mang đến cho người sử dụng.
3.3. Nguyên liệ u trong sả n xuấ t yoghurt
Yoghurt có thể được sản xuất từ sữa tươi, sữa bột, sữa cô đặc, sữa hoàn nguyên hoặc sữa tái chế. Sữa tươi sử dụng trong sản xuất yoghurt phải có chất lượng tốt, các yêu cầu quan trọng cho nguyên liệu sữa tươi như sau:
- Tổng số tế bào VSV trong sữa càng thấp càng tốt
- Không chứa thể thực khuẩn
- Không chứa kháng sinh
- Không chứa các enzyme
- Không chứa dư lượng hóa chất có nguồn gốc từ quá trình tẩy rửa và vệ sinh dụng cụ hoặc thiết bị đựng sữa
Hàm lượng chất béo trong sữa sẽ được hiệu chỉnh trong quá trình chuẩn hóa để
phù hợp theo yêu cầu của sản phẩm. Hàm lượng chất khô không thấp hơn 8,2% (theo quy định của WHO/FAO). Khi tăng hàm lượng chất khô trong sữa nguyên liệu, đặc biệt là tăng hàm lượng casein và protein huyết thanh sữa sẽ làm cho cấu trúc khối đông trở nên bền và ổn định hơn, tránh được hiện tượng tách huyết thanh trong sản phẩm yoghurt truyền thống.
Để tăng vị ngọt cho yoghurt, người ta bổ sung đường (glucose, saccharose…) vào sữa trong quá trình chế biến. Đường có thể được bổ sung trực tiếp hoặc dưới dạng puree trái cây đối với những sản phẩm dành cho người ăn kiêng, các nhà sản xuất sử dụng chất tạo ngọt, thông dụng nhất là aspartame.
Trái cây các loại như thơm, dâu, sơri, táo…được bổ sung vào yoghurt thường dưới dạng puree. Có hai dạng puree: puree tự nhiên (không có bổ sung thêm đường) và puree có bổ sung thêm đường. Hàm lượng đường trong puree thường chiếm 50 ÷ 55%.
Một số sản phẩm yoghurt còn được bổ sung thêm hương liệu và chất màu trong qua trình sản xuất. Tuỳ theo tình hình của mỗi quốc gia mà danh mục các phụ gia nguyên liệu và màu được phép sử dụng trong chế biến thực phẩm với liều lượng tối đa quy định có thể sẽ khác nhau.
Đối với một số sản phẩm, người ta có sử dụng chất ổn định để yoghurt có được cấu trúc, độ nhớt… theo yêu cầu. Các chất ổn định thường sử dụng là gelatin, pectin, agar-agar… chúng là những chất ưa nước và có thể liên kết với nước. Loại chất ổn định và hàm lượng sử dụng tối ưu cho từng sản phẩm sẽ được xác định bằng phương pháp thực nghiệm.
3.4. Quy trì nh công nghệ sả n xuấ t sữa chua yoghurt
3.4.1. Sơ đồ quy trình tổng quát sả n xuấ t sữa chua yoghurt
Quy trì nh công nghệ sả n xuấ t yoghurt thay đổ i phụ thuộ c và o dạ ng sả n phẩ m và mứ c giá trị cá c chỉ tiêu chấ t lượ ng cầ n đạ t , khái quát về sơ đồ quy trình công nghệ sản xuấ t mộ t số dạ ng yoghurt đượ c trình bày trong hì nh 5.10.
3.4.2. Thuyết minh quy trình công nghệ
a) Chuẩ n hó a
Mục đích : là hiệu chỉnh hàm lượng chất béo của nguyên liệu , để đảm bảo hàm lượng chất béo cho sản phẩm yoghurt, thường hàm lượng chất béo trong sản phẩm yoghurt dao động trong khoảng 0.5÷3.5%.
Nguyên tắc chuẩn hóa:
- Đối với nguyên liệu có hàm lượng chất béo thấp ta bổ sung cream. Phương pháp tính tỷ lệ phối trộn như sau:
Gọi : - M (kg) là khối lượng sữa với hàm lượng chất béo C % cầ n phố i trộ n (A>C>B);
- M1 (kg) là khối lượng cream vớ i hà m lượ ng chấ t bé o A%;
- M2 (kg) là khối lượng sữa vớ i hà m lượ ng chấ t bé o B%.
Ta có :
M M (C B) ,
1 A B
(5.3);
M M ( A C) ,
2 A B
(5.4);
M M1
M2
(5.5).
Ví dụ : cream có hà m lượ ng chấ t bé o 40%, sữ a nguyên liệ u có hà m lượ ng chấ t béo 3%. Cầ n phố i trộ n cream và sữ a nguyên liệ u theo tỷ lệ bao nhiêu để có đượ c
100kg sữ a vớ i hà m lượ ng chấ t bé o 3,5%?
Ta có : M = 100kg; A = 40%; B = 3%; C = 3,5%
Thay cá c giá trị trên và o công thứ c (5.3) và (5.4), ta đượ c:
M M (C B) 100 (3,5 3) 1,35 kg
1 A B 40 3
MM ( A C) 100 (40 3,5) 98,56 kg
2 A B 40 3
Vậ y ta cầ n bổ sung 1,35 kg cream 40% chấ t bé o và o 98,56 kg sữ a 3% chấ t bé o để thu được 100kg sữ a vớ i hà m lượ ng chấ t bé o 3,5%.
- Trườ ng hợ p sữ a nguyên liệ u có hà m lượ ng chấ t bé o cao , ta có thể bổ sung sữ a gầ y hoặ c sử dụ n g quá trì nh ly tâm để tá ch bớ t chấ t bé o khỏ i sữ a . Trong cá c dây chuyề n sả n xuấ t hiệ n đạ i , quá trình tách và hiệu chỉnh lượng chất béo trong sữa được thự c hiệ n hoà n toà n tự độ ng . Đầu tiên, sữ a già u bé o sẽ đượ c bơm và o máy ly tâm hoạt độ ng liên tụ c, khi đó hai sả n phẩ m là sữ a gầ y và cream đượ c thoá t ra . Hàm lượng chất béo trong hai sản phẩm này phụ thuộc vào chế độ hoạt động của máy ly tâm . Tiế p theo, mộ t phầ n cream sẽ đượ c phố i trộ n t rở lạ i vớ i sữ a gầ y để hà m lượ ng chấ t bé o trong hỗ n hợ p đạ t đú ng giá trị yêu cầ u . Phầ n cream dư sẽ đưa đi xử lý tiế p để hoà n thiệ n sả n phẩ m cream.
b) Hiệ u chỉ nh hà m lượ ng chấ t khô
Theo Bourgeois và Larpent (1989), tổ ng lượ ng chấ t khô tố i ưu cho quá trì nh lên men trong sả n xuấ t yoghurt là từ 14÷16%. Thự c tế , mỗ i nhà sả n xuấ t sẽ chọ n mộ t giá trị thích hợp cho sản phẩm của mình . Thông thườ ng, sữ a tươi có hà m lượ ng chấ t khô khoảng 11,5÷12,7%. Để tăng hà m lượ ng chấ t khô trong sữ a tươi , chuẩ n bị cho quá trình lên men, ta có thể chọ n mộ t trong nhữ ng giả i phá p thông dụ ng dướ i đây :
- Cô đặ c sữ a trong điề u kiệ n chân không để là m bay hơi đi mộ t lượ ng nướ c nhấ t đị nh. Thể tí ch sữ a sau quá trì nh cô đặ c thườ ng giả m từ 10÷20%. Khi đó , tổ ng lượ ng chấ t khô trong sữ a sẽ tăng từ 1,5÷3,0%.
- Bổ sung thêm bộ t sữ a gầ y và o sữ a tươi , hàm lượng bột sữa gầy sử dụng thường không cao hơn 3% so vớ i khố i lượ ng sữ a tươi.
- Bổ sung thêm sữ a cô đặ c và o sữ a tươi.
- Xử lý sữ a gầ y bằ ng phương phá p siêu lọ c trên thiế t bị màng lọc (membrane).
Dòng sản phẩm không qua màng thoát ra từ thiết bị siêu lọc có hàm lượng chất khô cao sẽ đượ c sử dụ ng để bổ sung và o sữ a tươi.
Tùy thuộc vào nguồn nguyên liệu và thiết bị sẵn có mà mỗi nhà máy sẽ chọn một giải pháp thích hợp cho việc hiệu chỉnh tổng hàm lượng chất khô trong nguyên liệu
sữ a tươi.
c) Bài khí
Hàm lượng chấ t khí hò a tan trong sữ a nguyên liệ u cà ng thấ p cà ng tố t . Khi đó , hiệ u quả củ a cá c quá trì nh đồ ng hó a và thanh trù ng sẽ tăng , các hợp chất bay hơi có mùi khó chịu trong sữa sẽ được tách bỏ và chất lượng sản phẩm yoghu rt sẽ tố t hơn.
Nế u cá c nhà má y bổ sung bộ t sữ a gầ y và o sữ a tươi để hiệ u chỉ nh hà m lượ ng chấ t khô, sự khuấ y trộ n hỗ n hợ p sẽ là m gia tăng lượ ng khí hò a tan trong sữ a . Khi đó , trong quy trì nh sả n xuấ t bắ t buộ c phả i có quá trình bài khí.





